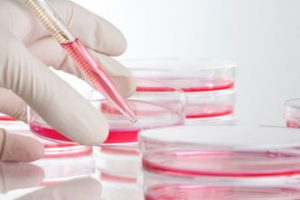
research-hp research

A common cancer pathway causing tumor growth is being targeted by a number of new cancer drugs and shows promising results. A team of researchers at Case Western Reserve University School of Medicine has developed a novel method to disrupt this growth-signaling pathway, with findings that suggest a new treatment for breast, colon, melanoma and other cancers.
The research team has pinpointed the cancer abnormality to a mutation in a gene called PIK3CA that results in a mutant protein, which may be an early cancer switch. By disrupting the mutated signaling pathway, the Case Western Reserve team, led by John Wang, associate professor in the Department of Genetics and Case Comprehensive Cancer Center, inhibited the growth of cancer cells, opening the possibility to new cancer therapies.
Their findings, "Gain of interaction with IRS1 by p110α helical domain mutants is crucial for their oncogenic functions,” was published May 2 in the journal Cancer Cell.
Cancer arises from a single cell, which has mutated in a small number of genes because of random errors in the DNA replication process. These mutations play key roles in carcinogenesis.
“This discovery has a broad impact on the treatment of human cancer patients because so many cancers are affected by this particular mutation in the p110α protein, which is encoded by the PIK3CA gene,” said Wang. “This is a significant advance because we can now disrupt this misdirected signaling pathway in cancer cells.
“If you turn on a light, you have to turn on a switch. But in the case of the mutation of this protein, p110α turns on by itself,” Wang said. “The mutation rewires the circuit and is uncontrolled. This implies that if you break these wires, you can control the growth of cancer. Our current discovery may lead to finding less toxic drugs that can be used for personalized treatment for cancer patients in the future.”
“This research will impact the field by focusing us on new targets for treating and preventing metastasis in patients in a many different types of human cancers,” said Stanton Gerson, the Asa and Patricia Shiverick-Jane Shiverick (Tripp) Professor of Hematological Oncology and director of Case Comprehensive Cancer Center and of Seidman Cancer Center at University Hospitals Case Medical Center.
Wang’s multidisciplinary team of Case Western Reserve researchers includes: Yujun Hao, Chao Wang, Bo Cao, Brett M. Hirsch, Jing Song, Sanford D. Markowitz, Rob M. Ewing, David Sedwick, Lili Liu and Weiping Zheng.
A common cancer pathway causing tumor growth is being targeted by a number of new cancer drugs and shows promising results. A team of researchers at Case Western Reserve University School of Medicine has developed a novel method to disrupt this growth-signaling pathway, with findings that suggest a new treatment for breast, colon, melanoma and other cancers.
The research team has pinpointed the cancer abnormality to a mutation in a gene called PIK3CA that results in a mutant protein, which may be an early cancer switch. By disrupting the mutated signaling pathway, the Case Western Reserve team, led by John Wang, associate professor in the Department of Genetics and Case Comprehensive Cancer Center, inhibited the growth of cancer cells, opening the possibility to new cancer therapies.
Their findings, "Gain of interaction with IRS1 by p110α helical domain mutants is crucial for their oncogenic functions,” was published May 2 in the journal Cancer Cell.
Cancer arises from a single cell, which has mutated in a small number of genes because of random errors in the DNA replication process. These mutations play key roles in carcinogenesis.
“This discovery has a broad impact on the treatment of human cancer patients because so many cancers are affected by this particular mutation in the p110α protein, which is encoded by the PIK3CA gene,” said Wang. “This is a significant advance because we can now disrupt this misdirected signaling pathway in cancer cells.
“If you turn on a light, you have to turn on a switch. But in the case of the mutation of this protein, p110α turns on by itself,” Wang said. “The mutation rewires the circuit and is uncontrolled. This implies that if you break these wires, you can control the growth of cancer. Our current discovery may lead to finding less toxic drugs that can be used for personalized treatment for cancer patients in the future.”
“This research will impact the field by focusing us on new targets for treating and preventing metastasis in patients in a many different types of human cancers,” said Stanton Gerson, the Asa and Patricia Shiverick-Jane Shiverick (Tripp) Professor of Hematological Oncology and director of Case Comprehensive Cancer Center and of Seidman Cancer Center at University Hospitals Case Medical Center.
Wang’s multidisciplinary team of Case Western Reserve researchers includes: Yujun Hao, Chao Wang, Bo Cao, Brett M. Hirsch, Jing Song, Sanford D. Markowitz, Rob M. Ewing, David Sedwick, Lili Liu and Weiping Zheng.School of Medicine researchers discover new target for personalized cancer therapy
A common cancer pathway causing tumor growth is being targeted by a number of new cancer drugs and shows promising results. A team of researchers at Case Western Reserve University School of Medicine has developed a novel method to disrupt this growth-signaling pathway, with findings that suggest a new treatment for breast, colon, melanoma and other cancers.
The research team has pinpointed the cancer abnormality to a mutation in a gene called PIK3CA that results in a mutant protein, which may be an early cancer switch. By disrupting the mutated signaling pathway, the Case Western Reserve team, led by John Wang, associate professor in the Department of Genetics and Case Comprehensive Cancer Center, inhibited the growth of cancer cells, opening the possibility to new cancer therapies.
Their findings, "Gain of interaction with IRS1 by p110α helical domain mutants is crucial for their oncogenic functions,” was published May 2 in the journal Cancer Cell.
Cancer arises from a single cell, which has mutated in a small number of genes because of random errors in the DNA replication process. These mutations play key roles in carcinogenesis.
“This discovery has a broad impact on the treatment of human cancer patients because so many cancers are affected by this particular mutation in the p110α protein, which is encoded by the PIK3CA gene,” said Wang. “This is a significant advance because we can now disrupt this misdirected signaling pathway in cancer cells.
“If you turn on a light, you have to turn on a switch. But in the case of the mutation of this protein, p110α turns on by itself,” Wang said. “The mutation rewires the circuit and is uncontrolled. This implies that if you break these wires, you can control the growth of cancer. Our current discovery may lead to finding less toxic drugs that can be used for personalized treatment for cancer patients in the future.”
“This research will impact the field by focusing us on new targets for treating and preventing metastasis in patients in a many different types of human cancers,” said Stanton Gerson, the Asa and Patricia Shiverick-Jane Shiverick (Tripp) Professor of Hematological Oncology and director of Case Comprehensive Cancer Center and of Seidman Cancer Center at University Hospitals Case Medical Center.
Wang’s multidisciplinary team of Case Western Reserve researchers includes: Yujun Hao, Chao Wang, Bo Cao, Brett M. Hirsch, Jing Song, Sanford D. Markowitz, Rob M. Ewing, David Sedwick, Lili Liu and Weiping Zheng.
A common cancer pathway causing tumor growth is being targeted by a number of new cancer drugs and shows promising results. A team of researchers at Case Western Reserve University School of Medicine has developed a novel method to disrupt this growth-signaling pathway, with findings that suggest a new treatment for breast, colon, melanoma and other cancers.
The research team has pinpointed the cancer abnormality to a mutation in a gene called PIK3CA that results in a mutant protein, which may be an early cancer switch. By disrupting the mutated signaling pathway, the Case Western Reserve team, led by John Wang, associate professor in the Department of Genetics and Case Comprehensive Cancer Center, inhibited the growth of cancer cells, opening the possibility to new cancer therapies.
Their findings, "Gain of interaction with IRS1 by p110α helical domain mutants is crucial for their oncogenic functions,” was published May 2 in the journal Cancer Cell.
Cancer arises from a single cell, which has mutated in a small number of genes because of random errors in the DNA replication process. These mutations play key roles in carcinogenesis.
“This discovery has a broad impact on the treatment of human cancer patients because so many cancers are affected by this particular mutation in the p110α protein, which is encoded by the PIK3CA gene,” said Wang. “This is a significant advance because we can now disrupt this misdirected signaling pathway in cancer cells.
“If you turn on a light, you have to turn on a switch. But in the case of the mutation of this protein, p110α turns on by itself,” Wang said. “The mutation rewires the circuit and is uncontrolled. This implies that if you break these wires, you can control the growth of cancer. Our current discovery may lead to finding less toxic drugs that can be used for personalized treatment for cancer patients in the future.”
“This research will impact the field by focusing us on new targets for treating and preventing metastasis in patients in a many different types of human cancers,” said Stanton Gerson, the Asa and Patricia Shiverick-Jane Shiverick (Tripp) Professor of Hematological Oncology and director of Case Comprehensive Cancer Center and of Seidman Cancer Center at University Hospitals Case Medical Center.
Wang’s multidisciplinary team of Case Western Reserve researchers includes: Yujun Hao, Chao Wang, Bo Cao, Brett M. Hirsch, Jing Song, Sanford D. Markowitz, Rob M. Ewing, David Sedwick, Lili Liu and Weiping Zheng.
